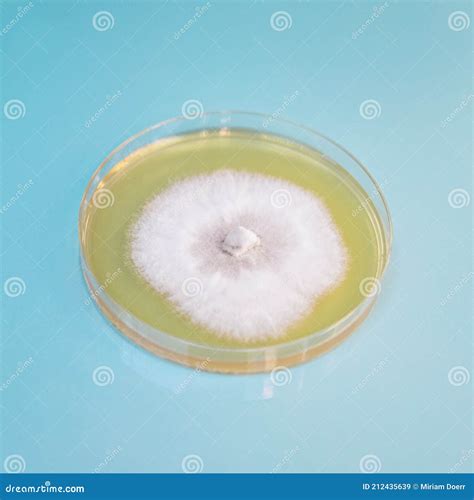
Piastra di Petri con micelio di fungo

La Placca di Petri, uno strumento apparentemente semplice, si rivela un pilastro fondamentale nel campo della coltivazione, in particolare nella micologia e nell'orticoltura. Offrendo un ambiente controllato e trasparente, essa consente un'osservazione dettagliata e isolata della crescita e dell'evoluzione di diversi organismi, fungendo da vero e proprio laboratorio portatile per ricercatori, coltivatori e appassionati. La sua trasparenza è cruciale per monitorare con precisione lo sviluppo del micelio, facilitando così indagini scientifiche e sperimentazioni in condizioni rigorosamente controllate. Questo aspetto è di primaria importanza quando si studiano i funghi, poiché permette di visualizzare la colonizzazione del substrato, la formazione del micelio e, infine, l'emergere delle strutture riproduttive, offrendo uno sguardo diretto sui processi biologici in atto.
Materiali Innovativi per una Durata e una Purezza Ineguagliabili
Il design della Placca di Petri, unito ai materiali impiegati nella sua fabbricazione, ne garantisce l'efficacia e la longevità. La scelta del vetro di borosilicato come materiale primario conferisce a questi strumenti una notevole resistenza, permettendo loro di sopportare sbalzi termici repentini senza subire alcuna alterazione strutturale. Questa caratteristica è di inestimabile valore nei contesti di coltivazione dove le condizioni ambientali possono variare significativamente, richiedendo attrezzature capaci di mantenere la loro integrità sotto stress termico. Inoltre, la superficie intrinsecamente liscia del vetro facilita enormemente le operazioni di pulizia, rendendo le piastre facilmente riutilizzabili per esperimenti futuri. Questa capacità di essere sterilizzate e riutilizzate non solo garantisce la purezza necessaria per esperimenti futuri, ma contribuisce anche a una gestione più sostenibile delle risorse in laboratorio.
Applicazioni Versatili nella Coltivazione Fungina e nell'Orticoltura
Nella coltivazione dei funghi, la Placca di Petri trascende la sua funzione di semplice contenitore per l'osservazione, diventando uno strumento multifunzionale. Oltre a permettere il monitoraggio dello sviluppo del micelio, è essenziale per la conservazione sterile di spore fungine per utilizzi futuri. Uno degli impieghi più significativi delle piastre di Petri in micologia è la clonazione dei funghi. La capacità di controllare le contaminazioni in questo ambiente asettico rende il processo di ottenimento di una coltura di micelio puro notevolmente più semplice e affidabile rispetto ad altre tecniche, come quelle che utilizzano la coltura liquida (LC). Organismi competitori, quali muffe e batteri, sono chiaramente visibili all'interno della piastra, consentendo di isolare e salvare il micelio desiderato semplicemente prelevando un frammento con un bisturi sterile.
Il principio fondamentale della clonazione di un fungo tramite Placca di Petri è analogo a quello utilizzato con la LC: si preleva un frammento di tessuto fungino, preferibilmente dalla parte interna, e lo si deposita su un substrato sterile, tipicamente agar. Nel giro di pochi giorni, il micelio inizierà a crescere dal frammento, espandendosi e colonizzando l'agar. Il passo successivo consiste nel prelevare un piccolo frammento di questo micelio in crescita e trasferirlo su una nuova piastra sterile, ottenendo così una coltura pura al 100%, priva di contaminanti.
Clonare un fungo con agar e petri
Per condurre con successo queste operazioni, è imperativo seguire rigorose procedure di igiene. Innanzitutto, è fondamentale lavarsi accuratamente le mani, idealmente con sapone antibatterico, o ancor meglio, utilizzare guanti di lattice monouso, disinfettandoli successivamente con alcool isopropilico. Poiché il tessuto deve essere prelevato dalla parte interna del fungo, è consigliabile romperlo a metà, senza tagliarlo, per evitare che la parte centrale entri in contatto con il bisturi, che potrebbe veicolare contaminanti presenti sulla superficie esterna. Nel caso di funghi con una consistenza particolarmente elastica o dura, che rendono difficile la rottura manuale (come ad esempio un Pleurotus ostreatus adulto), è possibile incidere leggermente solo lo strato superficiale del fungo con il bisturi, per poi spezzarlo con le mani e prelevare il frammento dalla parte centrale, che non è stata toccata dalla lama.
Lavorando in prossimità di una cappa a flusso laminare, è essenziale fare attenzione a non interporre la mano tra il filtro dell'aria e il fungo, poiché ciò potrebbe causare contaminazioni. Per massimizzare le probabilità di successo, è buona norma depositare più frammenti di tessuto in ogni piastra. Se compaiono batteri o muffe, è cruciale trasferire immediatamente un piccolo triangolino di micelio su un'altra piastra sterile e attendere che il micelio si riprenda e riprenda la crescita. Con le specie più aggressive, questo recupero può avvenire già dal secondo giorno.
Dopo l'inoculazione, le piastre devono essere sigillate ermeticamente per prevenire l'ingresso di contaminanti esterni. Un metodo efficace per questo scopo è l'utilizzo di Parafilm, una pellicola cerata estensibile che crea una sigillatura sicura e traspirante. Sebbene il Parafilm sia un investimento iniziale, un singolo rotolo è sufficiente per migliaia di piastre, rendendolo una soluzione economica nel lungo termine.
Una volta che la piastra di Petri è stata inoculata e sigillata, non resta che attendere. Nel giro di pochi giorni, si dovrebbe osservare la crescita di organismi. Se le procedure asettiche sono state rispettate, è altamente probabile che il micelio diventi visibile entro pochi giorni. Nel caso in cui si noti la comparsa simultanea di muffe o batteri insieme al micelio, è fondamentale trasferire tempestivamente un piccolo campione di agar colonizzato su una piastra sterile e attendere la ricrescita. Se, invece, si osserva esclusivamente la crescita di micelio, è possibile attendere qualche giorno in più prima di procedere al trasferimento.
Dopo un periodo di alcuni giorni dal trasferimento su una piastra pulita (nel caso specifico, 7 giorni), la crescita del micelio riprende vigorosamente, aggredendo rapidamente l'agar della nuova piastra. Esistono innumerevoli tipi di organismi che possono proliferare su un substrato di agar; per un approfondimento, sarebbe utile consultare testi di biologia generale. Tuttavia, nel contesto della coltivazione di funghi commestibili, ci si può concentrare sui contaminanti più comuni.
I tre contaminanti più frequenti sono le muffe, i lieviti e i batteri. Le muffe e i lieviti appartengono al regno dei funghi, mentre i batteri costituiscono un regno a sé stante. Le muffe si manifestano tipicamente come chiazze pelose di colore variabile (nero, verde, giallo, rosa, ecc.). Inizialmente, il loro colore può essere bianco, il che può indurre in errore, facendo credere che si tratti di micelio fungino. La parte colorata della muffa è costituita da spore, che possono facilmente diffondersi su tutta la piastra, compromettendo la coltura. In altre situazioni, si può osservare una chiazza di batteri che ha circondato un piccolo frammento di fungo pioppino (Agrocybe cylindracea). Ciononostante, in alcuni casi, il micelio è stato in grado di superare la chiazza batterica e bloccarne lo sviluppo, portando persino alla formazione di minuscoli primordi sul frammento di tessuto originale. Spesso, il micelio di specie fungine particolarmente aggressive è in grado di aggirare completamente le chiazze di lievito, bloccandone la crescita, o addirittura di inglobarle direttamente.
Durante la fase di colonizzazione, le piastre di Petri prive di contaminanti possono essere conservate a temperatura ambiente, mantenendole capovolte per prevenire la formazione di condensa sulla superficie interna del coperchio. Una volta che le colture sono pronte per la conservazione a lungo termine, possono essere riposte in frigorifero, dove mantengono la loro vitalità per un anno o più prima di disidratarsi. È importante notare che in frigorifero le piastre non devono essere conservate capovolte; altrimenti, si rischia di ritrovarsi con una notevole quantità di acqua accumulata al loro interno nel giro di pochi giorni, a causa della condensazione.

Le piastre di Petri pronte all'uso, contenenti un substrato di agar sterile, rappresentano il medium ideale per la coltivazione del micelio. Queste piastre sono preparate in ambienti asettici, perfette per espandere colture di micelio o per far germinare spore. L'agar, dopo essere stato sterilizzato in autoclave a 121°C, viene versato sulle piastre di Petri da 90mm a tripla ventilazione, anch'esse sterili. Successivamente, le piastre vengono fatte raffreddare sotto una cappa a flusso laminare dotata di filtro HEPA certificato. Infine, vengono sigillate con Parafilm per assicurarne la protezione da agenti esterni e garantire la massima qualità e sterilità del prodotto. È importante segnalare che un lieve grado di condensa all'interno delle piastre potrebbe essere presente qualora si siano verificate fluttuazioni di temperatura durante il trasporto, un fenomeno normale e non indicativo di un difetto del prodotto.